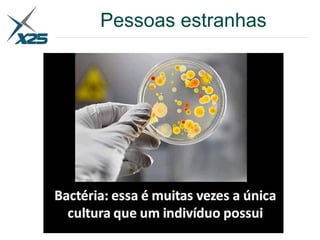
Pessoas estranhas

O documento apresenta uma palestra sobre empregabilidade em TI. A palestra discute a evolução das tecnologias ao longo dos anos, desde os anos 1980 até os dias atuais, e como os profissionais de TI precisam se adaptar constantemente às novas tendências tecnológicas para se manterem empregáveis. A palestra também dá dicas sobre liderança, aprendizado contínuo e mentalidade de crescimento para quem trabalha com tecnologia.